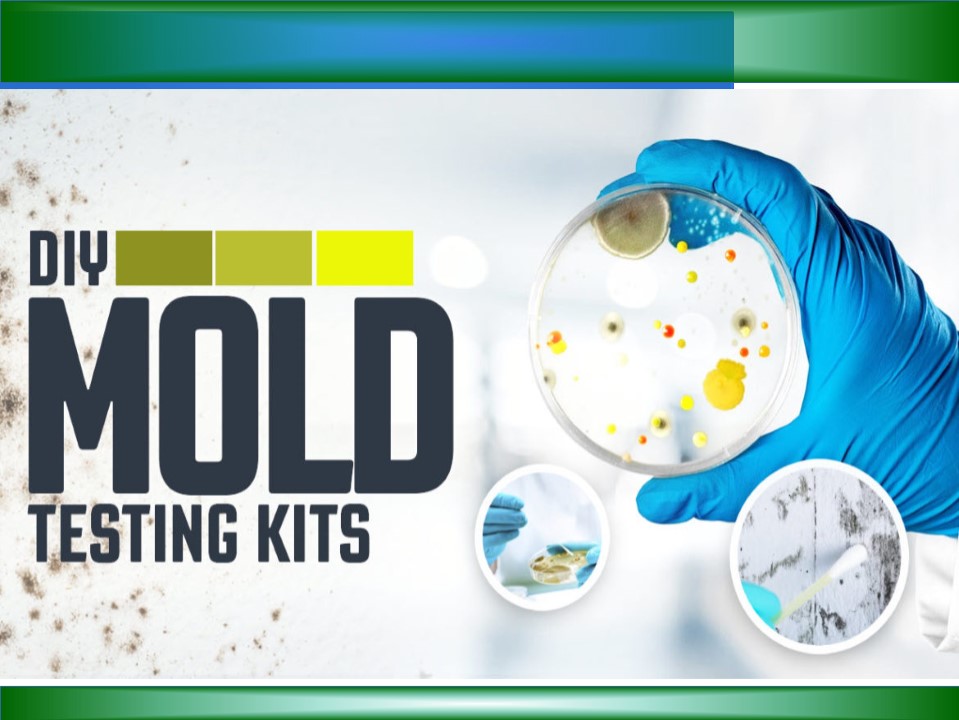

Professional Mold Testing PowerPoint PPT Presentation
Title: Professional Mold Testing
1
(No Transcript)
2
About Us
The Mold Facts is a leading information portal
with a unique selection of guides, resources, and
articles about mold and allergies. From learning
about mold and allergies to the latest HEPA
filters and Air purifiers to choosing the right
DIY mold testing kits, you can find exclusive
mold-related information online here.
3
Mold Testing Kits
Bring DIY mold testing kits to quickly identify
airborne and surface mold spores. For more
information on mold testing, visit
Themoldfacts.com.
4
How Much Does Mold Removal Cost?
How much does mold removal cost? Typical costs
may vary between 800 and 2500. However, you
should consult mold experts on 866-674-7541 for
the best quotes. Visit Themoldfacts.com.
5
Contact Us
5318 Canoga Ave. Unit A, Woodland Hills, CA USA
6
Thank You
PowerShow.com is a leading presentation sharing website. It has millions of presentations already uploaded and available with 1,000s more being uploaded by its users every day. Whatever your area of interest, here you’ll be able to find and view presentations you’ll love and possibly download. And, best of all, it is completely free and easy to use.
You might even have a presentation you’d like to share with others. If so, just upload it to PowerShow.com. We’ll convert it to an HTML5 slideshow that includes all the media types you’ve already added: audio, video, music, pictures, animations and transition effects. Then you can share it with your target audience as well as PowerShow.com’s millions of monthly visitors. And, again, it’s all free.
About the Developers
PowerShow.com is brought to you by CrystalGraphics, the award-winning developer and market-leading publisher of rich-media enhancement products for presentations. Our product offerings include millions of PowerPoint templates, diagrams, animated 3D characters and more.